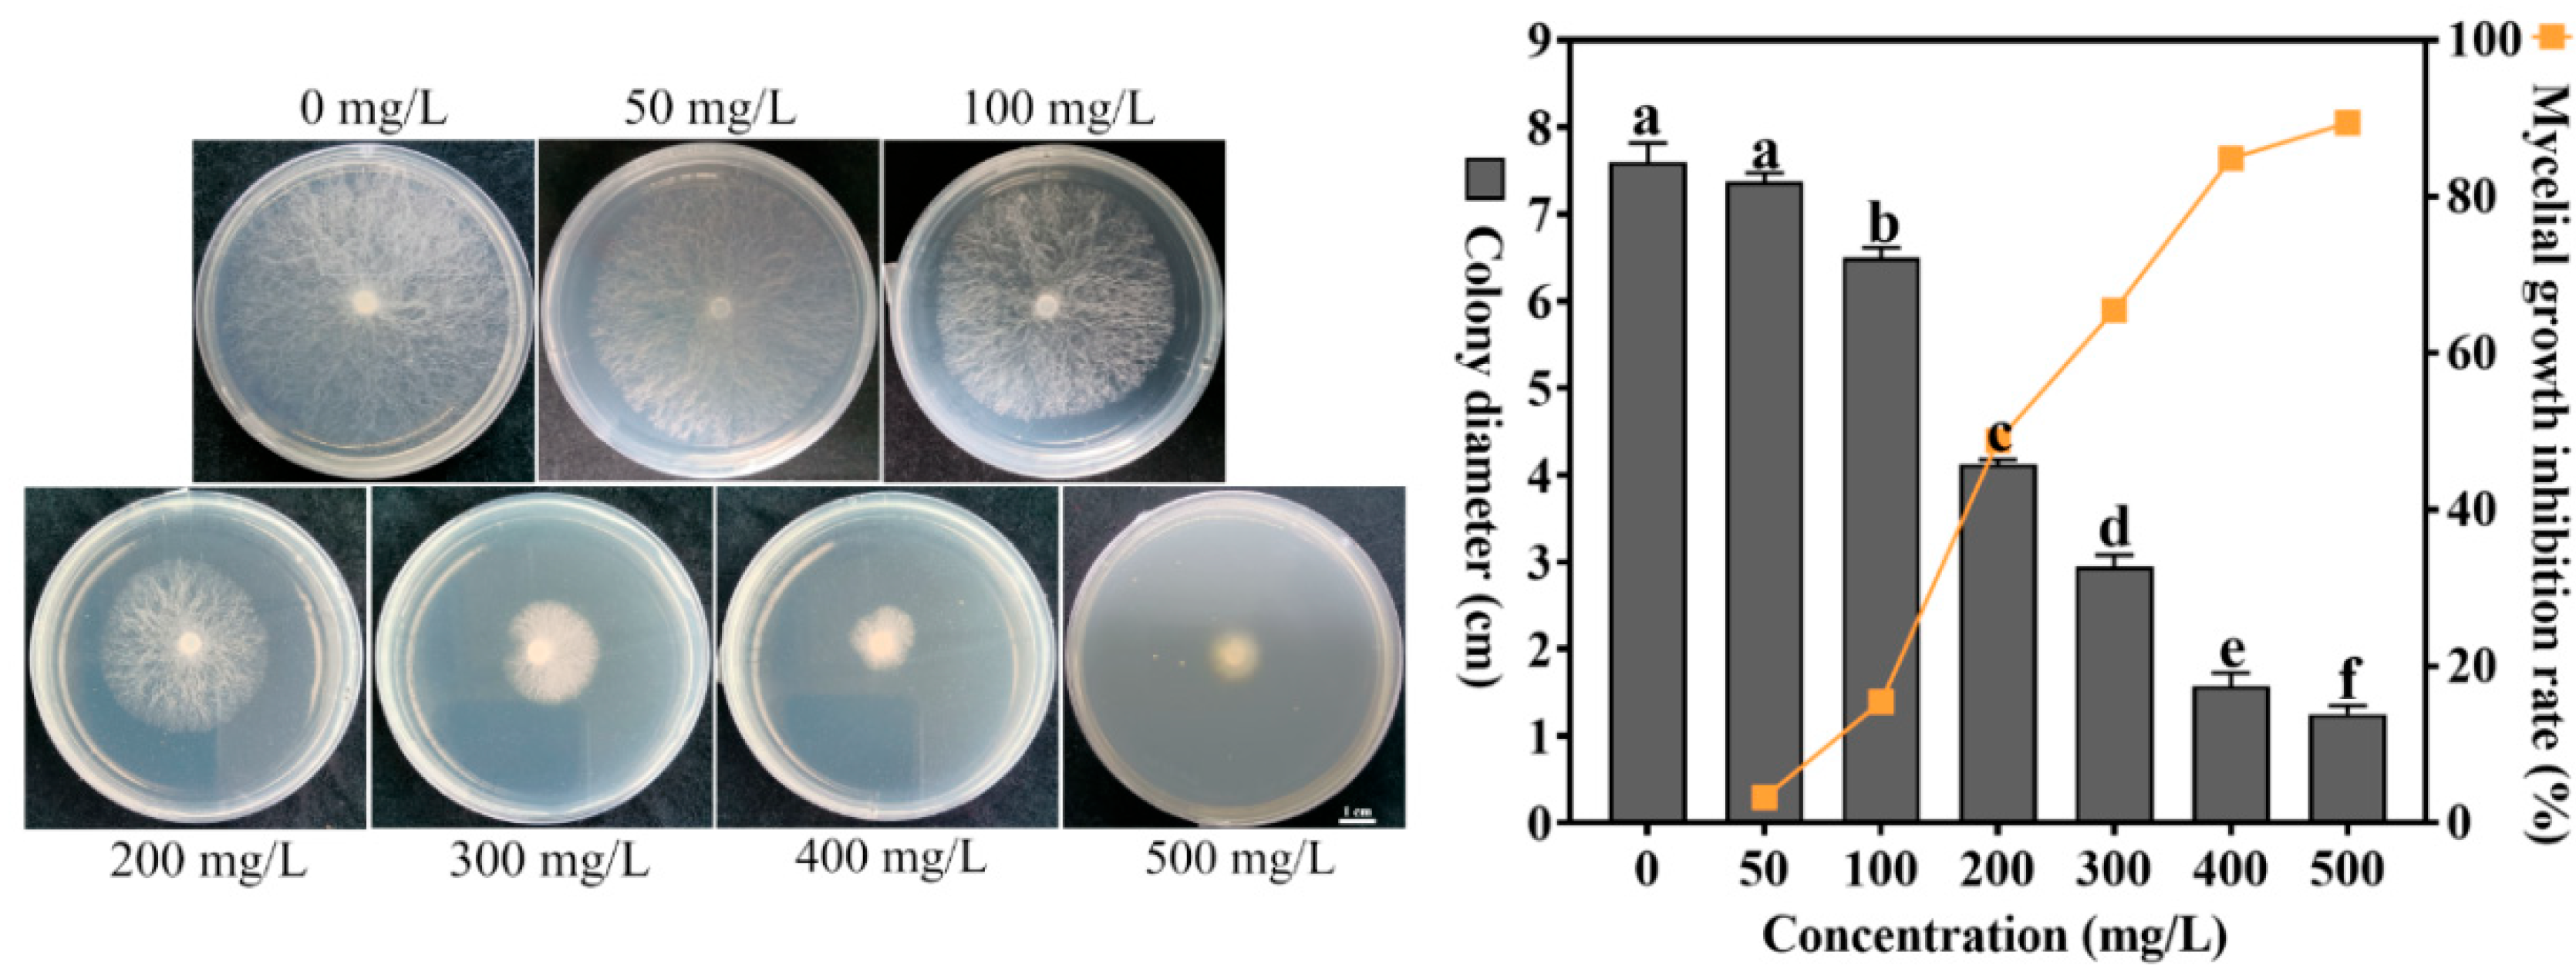
Agronomy 15 01764 g001
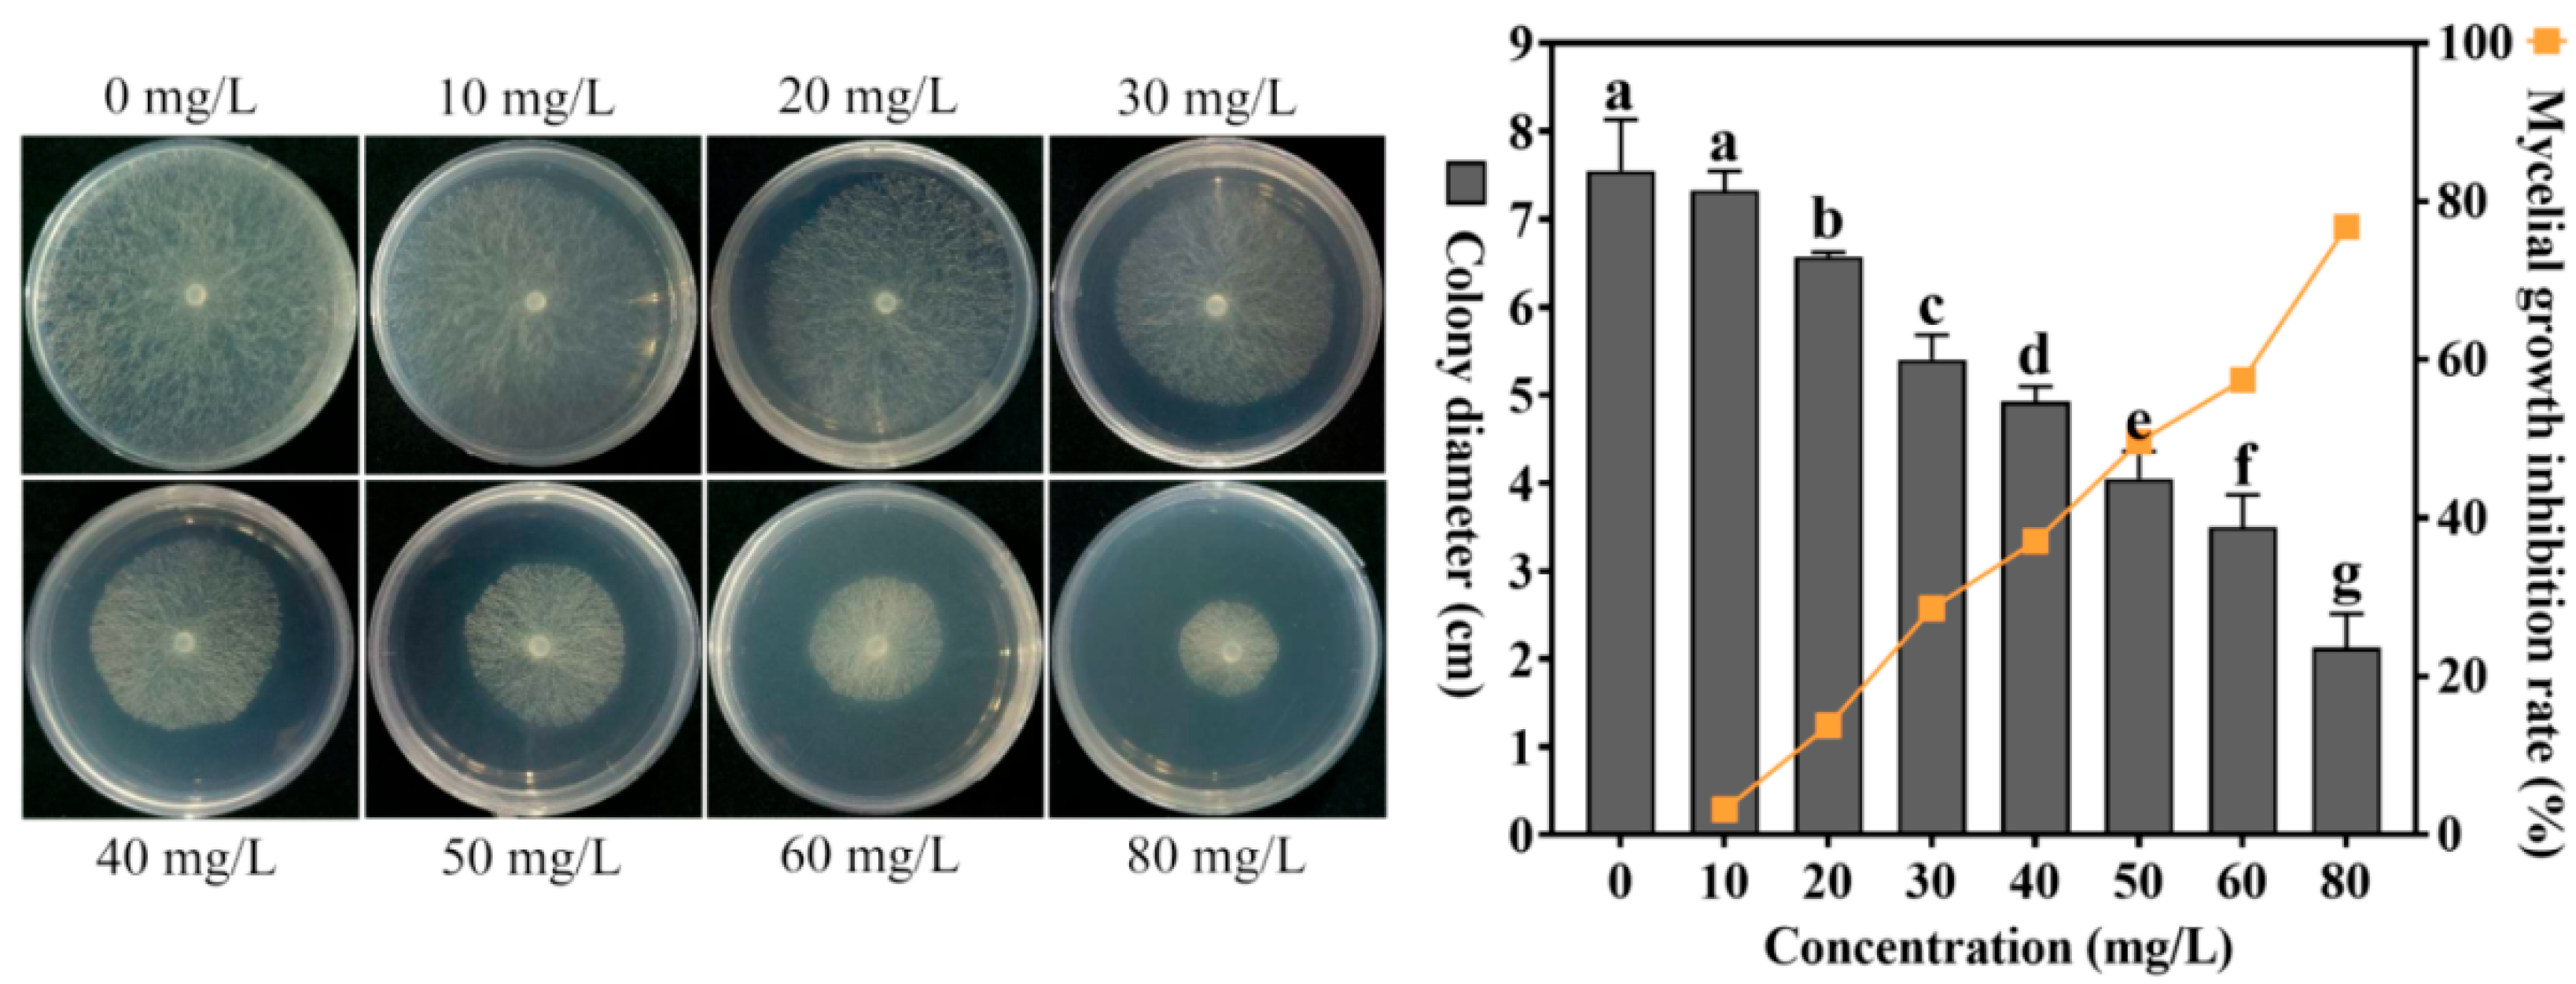
Agronomy 15 01764 g002
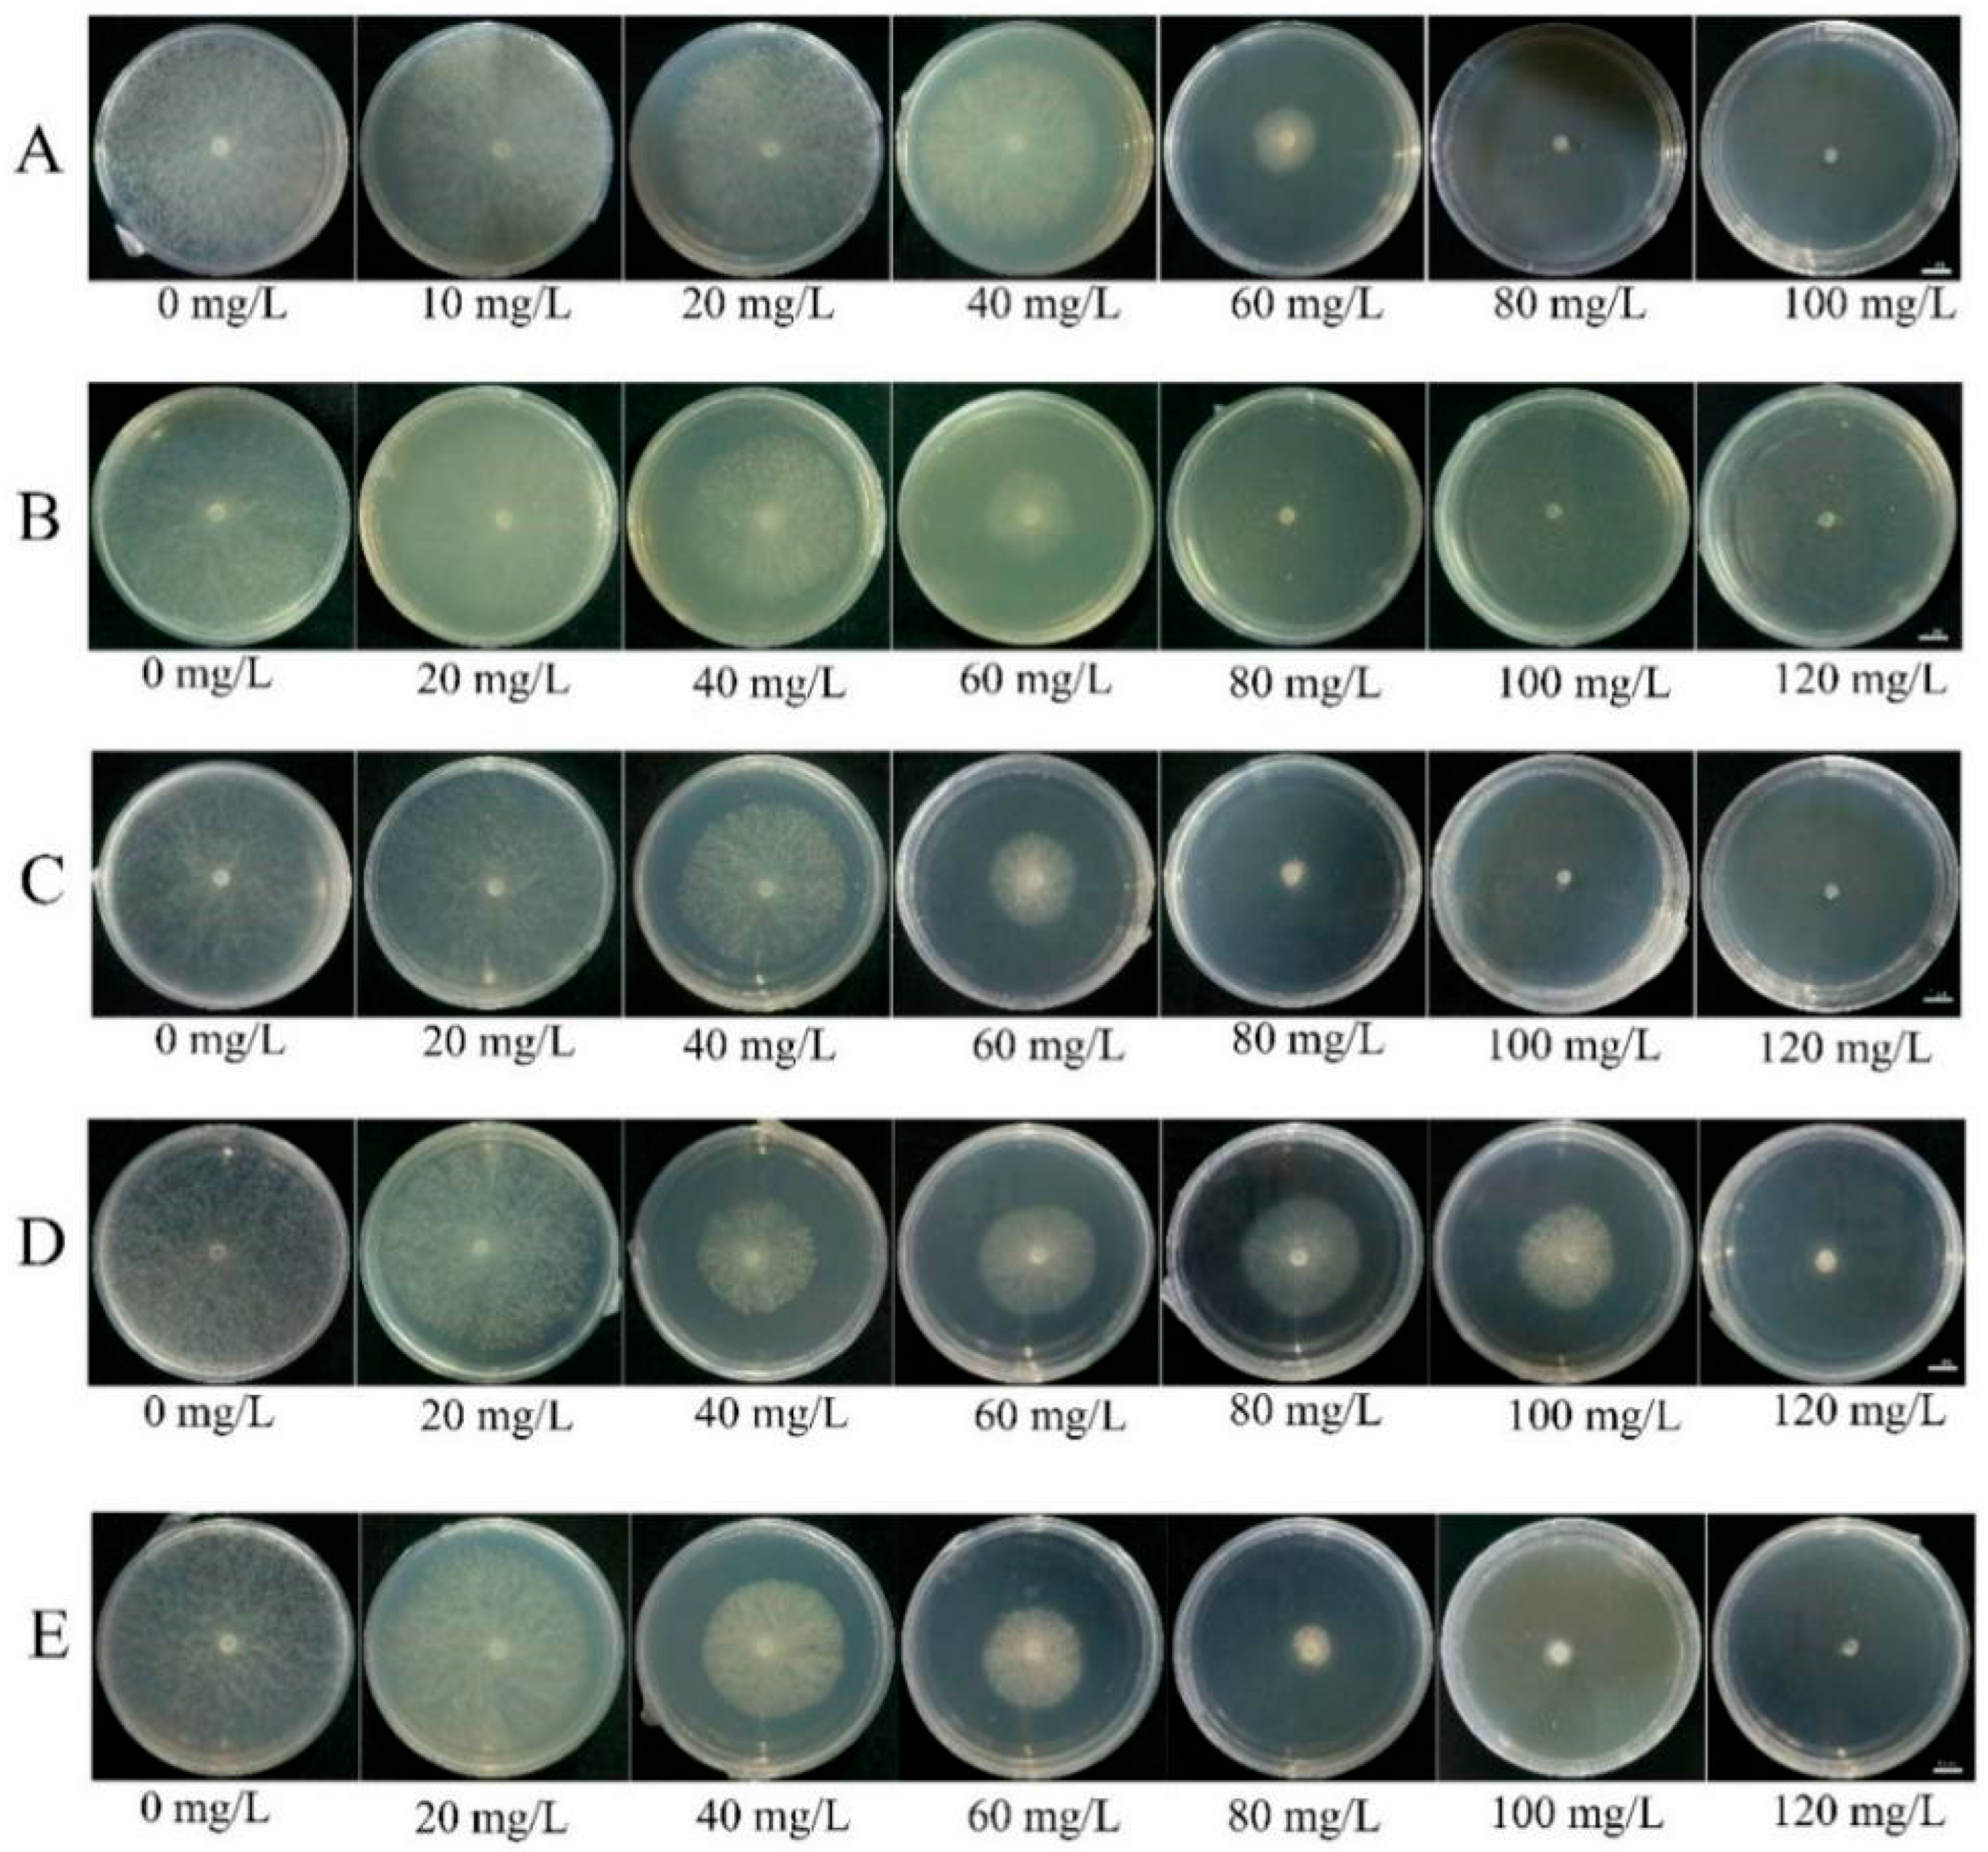
Agronomy 15 01764 g003

Inhibitory Effects and Underlying Mechanisms of a Selenium Compound Agent Against the Pathogenic Fungus Sclerotinia sclerotiorum Causing Sclerotinia Stem Rot in Brassica napus
Abstract
1. Introduction
2. Experimental Design
3. Materials and Methods
3.1. Strains, Media and Fungicide
3.2. Sensitivity to Sodium Selenate and Cuminic Acid
3.3. Screening of Compound Agent Formulations
3.4. Scanning Electron Microscopy (SEM) Observation of Mycelial Morphology
3.5. Effects of Selenium Compound Agent on Physiological and Biochemical Indexes of Mycelium
3.6. Transcriptomic Analysis of the Mycelium Treated with Selenium Compound Agent
3.7. Therapeutic Effect of Selenium Compound Agent on SSR in Rapeseed
3.8. Statistical Analysis
4. Results
4.1. Effect of Different Concentrations of Sodium Selenite on the Growth of S. sclerotiorum
4.2. Effect of Different Concentrations of Cuminic Acid on the Growth of S. sclerotiorum
4.3. Compound Agent Formulation Screening
4.4. Effects of Selenium Compound Agent on the Hyphal Morphology of S. sclerotiorum
4.5. Effects of Selenium Compound Agent on Physiological and Biochemical Indexes of S. sclerotiorum
4.6. Transcriptomic Analysis
4.7. Control Efficacy of the Selenium Compound Agent on SSR of Rapeseed
5. Discussion
6. Conclusions
Supplementary Materials
Author Contributions
Funding
Institutional Review Board Statement
Data Availability Statement
Acknowledgments
Conflicts of Interest
References
- Yaderets, V.V.; Karpova, N.V.; Glagoleva, E.V.; Ovchinnikov, A.I.; Petrova, K.S.; Dzhavakhiya, V.V. Inhibition of the Growth and Development of Sclerotinia sclerotiorum (Lib.) De Bary by Combining Azoxystrobin, Penicillium chrysogenum VKM F-4876d, and Bacillus Strains. Agronomy 2021, 11, 2520. [Google Scholar] [CrossRef]
- Liang, X.; Rollins, J.A. Mechanisms of broad host range necrotrophic pathogenesis in Sclerotinia sclerotiorum. Phytopathology 2018, 108, 1128–1140. [Google Scholar] [CrossRef] [PubMed]
- Jia, W.; Hu, C.X.; Ming, J.J.; Zhao, Y.Y.; Xin, J.; Sun, X.C.; Zhao, X.H. Action of selenium against Sclerotinia sclerotiorum: Damaging membrane system and interfering with metabolism. Pestic. Biochem. Physiol. 2018, 150, 10–16. [Google Scholar] [CrossRef] [PubMed]
- Feng, Y.X.; Hu, Y.X.; Fang, P.P.; Zuo, X.J.; Wang, J.X.; Li, J.N.; Qian, W.; Mei, J.Q. Silicon alleviates the disease severity of sclerotinia stem rot in rapeseed. Front. Plant Sci. 2021, 12, 721436. [Google Scholar] [CrossRef] [PubMed]
- Boyd, R.S. The defense hypothesis of elemental hyperaccumulation: Status, challenges and new directions. Plant Soil 2007, 293, 153–176. [Google Scholar] [CrossRef]
- Hörger, A.C.; Fones, H.N.; Preston, G.M. The current status of the elemental defense hypothesis in relation to pathogens. Front. Plant Sci. 2013, 4, 395. [Google Scholar] [CrossRef] [PubMed]
- Pandey, S.S. The role of iron in phytopathogenic microbe–plant interactions: Insights into virulence and host immune response. Plants 2023, 12, 3173. [Google Scholar] [CrossRef] [PubMed]
- Elsherbiny, E.A.; Taher, M.A. Silicon induces resistance to postharvest rot of carrot caused by Sclerotinia sclerotiorum and the possible of defense mechanisms. Postharvest Biol. Technol. 2018, 140, 11–17. [Google Scholar] [CrossRef]
- Xue, T.L.; Hartikainen, H.; Piironen, V. Antioxidative and growth-promoting effect of selenium on senescing lettuce. Plant Soil 2001, 237, 55–61. [Google Scholar] [CrossRef]
- Chu, J.Z.; Yao, X.Q.; Yue, Z.W.; Li, J.M.; Zhao, J.H. The effects of selenium on physiological traits, grain selenium content and yield of winter wheat at different development stages. Biol. Trace Elem. Res. 2013, 151, 434–440. [Google Scholar] [CrossRef] [PubMed]
- Lin, L.; Zhou, W.H.; Dai, H.X.; Cao, F.B.; Zhang, G.P.; Wu, F.B. Selenium reduces cadmium uptake and mitigates cadmium toxicity in rice. J. Hazard. Mater. 2012, 235, 343–351. [Google Scholar] [CrossRef] [PubMed]
- Mozafariyan, M.; Shekari, L.; Hawrylak-Nowak, B.; Kamelamnesh, M.M. Protective role of selenium on pepper exposed to cadmium stress during reproductive stage. Biol. Trace Elem. Res. 2014, 160, 97–107. [Google Scholar] [CrossRef] [PubMed]
- Qing, X.J.; Zhao, X.H.; Hu, C.X.; Wang, P.; Zhang, Y.; Zhang, X.; Wang, P.C.; Shi, H.Z.; Jia, F.; Qu, C. Selenium alleviates chromium toxicity by preventing oxidative stress in cabbage (Brassica campestris, L. ssp. Pekinensis) leaves. Ecotoxicol. Environ. Saf. 2015, 114, 179–189. [Google Scholar] [CrossRef] [PubMed]
- Cheng, Q.; Hu, C.X.; Jia, W.; Cai, M.M.; Zhao, Y.Y.; Tang, Y.N.; Yang, D.D.; Zhou, Y.J.; Sun, X.C.; Zhao, X.H. Selenium reduces the pathogenicity of Sclerotinia sclerotiorum by inhibiting sclerotial formation and germination. Ecotoxicol. Environ. Saf. 2019, 183, 109503. [Google Scholar] [CrossRef] [PubMed]
- Liu, L.N.; Wang, C.Y.; Yin, K.S.; Ni, M.; Ding, Y.; Li, C.Y.; Zheng, S.J. The Dual Effect of Selenium Application in Reducing Fusarium Wilt Disease Incidence in Banana and Producing Se-Enriched Fruits. Plants 2024, 13, 3435. [Google Scholar] [CrossRef] [PubMed]
- Espinosa-Ortiz, E.J.; Gonzalez-Gil, G.; Saikaly, P.E.; van Hullebusch, E.D.; Lens, P.N. Effects of selenium oxyanions on the white-rot fungus Phanerochaete chrysosporium. Appl. Microbiol. Biotechnol. 2015, 99, 2405–2418. [Google Scholar] [CrossRef] [PubMed]
- Wu, Z.L.; Yin, X.B.; Bañuelos, G.S.; Lin, Z.Q.; Zhu, Z.; Liu, Y.; Yuan, L.X.; Li, M. Effect of selenium on control of postharvest gray mold of tomato fruit and the possible mechanisms involved. Front. Microbiol. 2016, 6, 1441. [Google Scholar] [CrossRef] [PubMed]
- Wu, Z.L.; Yin, X.B.; Lin, Z.Q.; Bañuelos, G.S.; Yuan, L.X.; Liu, Y.; Li, M. Inhibitory effect of selenium against Penicillium expansum and its possible mechanisms of action. Curr. Microbiol. 2014, 69, 192–201. [Google Scholar] [CrossRef] [PubMed]
- Ma, X.H.; Xu, J.Y.; Zhao, X.H.; Qu, L.L.; Gao, Y.; Huang, W.X.; Han, D.; Dang, B.J.; Xu, Z.C.; Jia, W. Selenium improves the control efficacy of Phytophthora nicotianae by damaging the cell membrane system and promoting plant energy metabolism. J. Agric. Food Chem. 2024, 72, 5073–5087. [Google Scholar] [CrossRef] [PubMed]
- Özer, G.; Türkkan, M.; Sönmez, F.; Kabakcı, H.; Alkan, M.; Derviş, S. In Vitro Evaluation of Selenium Against Some Plant Pathogenic Fungi. Akad. Ziraat Derg. 2024, 13, 99–110. [Google Scholar] [CrossRef]
- Wang, J.L.; Ma, Y.; Gao, Q.; Lu, Z.J.; Zhang, J.M. Overview of Active Components and Applications of Plant Derived Fungicides in China. J. Zhejiang Agric. Sci. 2025, 66, 138–145. [Google Scholar] [CrossRef]
- Wang, Y.; Zhang, J.; Sun, Y.; Feng, J.T.; Zhang, X. Evaluating the Potential Value of Natural Product Cuminic Acid against Plant Pathogenic Fungi in Cucumber. Molecules 2017, 22, 1914. [Google Scholar] [CrossRef] [PubMed]
- Yang, Z.H.; Qiu, Y.G.; Jin, D.J.; Zheng, Y.M.; Cui, Z.N.; Li, J.; Gu, W. Design, synthesis, and antifungal evaluation of novel cuminic acid derivatives as potential laccase inhibitors. J. Agric. Food Chem. 2024, 72, 27726–27736. [Google Scholar] [CrossRef] [PubMed]
- Hu, L.F.; He, J.; Feng, J.T.; Zhang, X. Optimization of supercritical CO2 extraction characterization of antifungal activity of essential oils in Cuminum cyminum, L. Aust. J. Crop Sci. 2013, 7, 1809–1813. [Google Scholar]
- Wang, Y.; Sun, Y.; Zhang, Y.; Zhang, X.; Feng, J.T. Antifungal activity and biochemical response of cuminic acid against Phytophthora capsici Leonian. Molecules 2016, 21, 756. [Google Scholar] [CrossRef] [PubMed]
- Sun, Y.; Wang, Y.; Han, L.R.; Zhang, X.; Feng, J.T. Antifungal activity action mode of cuminic acid from the seeds of Cuminum cyminum, L. against Fusarium oxysporum f. sp. Niveum (FON) causing Fusarium wilt on watermelon. Molecules 2017, 22, 2053. [Google Scholar] [CrossRef] [PubMed]
- Wang, Y.; Sun, Y.; Han, L.R.; Zhang, X.; Feng, J.T. Potential use of cuminic acid as a botanical fungicide against Valsa mali. Microb. Pathog. 2017, 106, 9–15. [Google Scholar] [CrossRef] [PubMed]
- Ma, H.X.; Feng, X.J.; Chen, Y.; Chen, C.J.; Zhou, M.G. Occurrence and characterization of dimethachlon insensitivity in Sclerotinia sclerotiorum in Jiangsu Province of China. Plant Dis. 2009, 93, 36–42. [Google Scholar] [CrossRef] [PubMed]
- Kuang, J.; Wang, J.X.; Zhou, M.G. Monitoring on carbendazim and dimethachlon-resistance of Sclerotinia sclerotiorum obtained from the blight stems of rape in Jiangsu Province. Chin. Agric. Sci. Bull. 2011, 27, 285–291. [Google Scholar] [CrossRef]
- Zhou, F.; Zhang, X.L.; Li, J.L.; Zhu, F.X. Dimethachlon resistance in Sclerotinia sclerotiorum in China. Plant Dis. 2014, 98, 1221–1226. [Google Scholar] [CrossRef] [PubMed]
- Zhao, W.B.; Zhao, Z.M.; Ma, Y.; Li, A.P.; Zhang, Z.J.; Hu, Y.M.; Zhou, Y.; Wang, R.; Luo, X.F.; Zhang, B.Q.; et al. Antifungal activity and preliminary mechanism of pristimerin against Sclerotinia sclerotiorum. Ind. Crops Prod. 2022, 185, 115124. [Google Scholar] [CrossRef]
- Kuang, J.; Hou, Y.P.; Wang, J.X.; Zhou, M.G. Sensitivity of Sclerotinia sclerotiorum to fludioxonil: In vitro determination of baseline sensitivity and resistance risk. Crop Prot. 2011, 30, 876–882. [Google Scholar] [CrossRef]
- Wang, W.Q.; Zhang, P.; Meng, R.J.; Zhao, J.J.; Huang, Q.L.; Han, X.Y.; Ma, Z.Q.; Zhang, X.F. Fungitoxicity and synergism of mixtures of fluopicolide and pyraclostrobin against Phytophthora infestans. Crop Prot. 2014, 57, 48–56. [Google Scholar] [CrossRef]
- Soylu, E.M.; Kurt, Ş.; Soylu, S. In vitro and in vivo antifungal activities of the essential oils of various plants against tomato grey mould disease agent Botrytis cinerea. Int. J. Food Microbiol. 2010, 143, 183–189. [Google Scholar] [CrossRef] [PubMed]
- Zhao, S.L.; Li, P.; Zhang, Q.K.; Zhang, J.H.; Kong, L.Z. Production of reducing sugar from corn stover by dilute acid hydrolysis co-catalyzed with metal salts under microwave radiation. Res. Chem. Intermed. 2013, 39, 3803–3812. [Google Scholar] [CrossRef]
- Crowther, T.; Collin, H.A.; Smith, B.; Tomsett, A.B.; O’Connor, D.; Jones, M.G. Assessment of the flavour of fresh uncooked onions by taste-panels and analysis of flavour precursors, pyruvate and sugars. J. Sci. Food Agric. 2005, 85, 112–120. [Google Scholar] [CrossRef]
- Duan, Y.B.; Ge, C.Y.; Liu, S.M.; Chen, C.J.; Zhou, M.G. Effect of phenylpyrrole fungicide fludioxonil on morphological and physiological characteristics of Sclerotinia sclerotiorum. Pestic. Biochem. Physiol. 2013, 106, 61–67. [Google Scholar] [CrossRef]
- Xu, C.Y.; Hou, Y.P.; Wang, J.X.; Yang, G.F.; Liang, X.Y.; Zhou, M.G. Activity of a novel strobilurin fungicide benzothiostrobin against Sclerotinia sclerotiorum. Pestic. Biochem. Physiol. 2014, 115, 32–38. [Google Scholar] [CrossRef] [PubMed]
- Andrews, S. FastQC: A Quality Control Tool for High Throughput Sequence Data. 2010. Available online: https://www.bioinformatics.babraham.ac.uk/projects/fastqc/ (accessed on 12 December 2024).
- Martin, M. Cutadapt removes adapter sequences from high-throughput sequencing reads. EMBnet. J. 2011, 17, 10–12. [Google Scholar] [CrossRef]
- Amselem, J.; Cuomo, C.A.; van Kan, J.A.L.; Viaud, M.; Benito, E.P.; Couloux, A.; Coutinho, P.M.; de Vries, R.P.; Dyer, P.S.; Fillinger, S.; et al. Genomic analysis of the necrotrophic fungal pathogens Sclerotinia sclerotiorum and Botrytis cinerea. PLoS Genet. 2011, 7, e1002230. [Google Scholar] [CrossRef] [PubMed]
- Kim, D.; Langmead, B.; Salzberg, S.L. HISAT: A fast spliced aligner with low memory requirements. Nat. Methods 2015, 12, 357–360. [Google Scholar] [CrossRef] [PubMed]
- Liao, Y.; Smyth, G.K.; Shi, W. featureCounts: An efficient general purpose program for assigning sequence reads to genomic features. Bioinformatics 2014, 30, 923–930. [Google Scholar] [CrossRef] [PubMed]
- Pertea, M.; Pertea, G.M.; Antonescu, C.M.; Chang, T.C.; Mendell, J.T.; Salzberg, S.L. StringTie enables improved reconstruction of a transcriptome from RNA-seq reads. Nat. Biotechnol 2015, 33, 290–295. [Google Scholar] [CrossRef] [PubMed]
- Robinson, M.D.; McCarthy, D.J.; Smyth, G.K. edgeR: A Bioconductor package for differential expression analysis of digital gene expression data. Bioinformatics 2010, 26, 139–140. [Google Scholar] [CrossRef] [PubMed]
- Young, M.D.; Wakefield, M.J.; Smyth, G.K.; Oshlack, A. Gene ontology analysis for RNA-seq: Accounting for selection bias. Genome Biol. 2010, 11, R14. [Google Scholar] [CrossRef] [PubMed]
- Mao, X.Z.; Cai, T.; Olyarchuk, J.G.; Wei, L.P. Automated genome annotation and pathway identification using the KEGG Orthology (KO) as a controlled vocabulary. Bioinformatics 2005, 21, 3787–3793. [Google Scholar] [CrossRef] [PubMed]
- Liang, X.Y.; Zou, L.J.; Lian, W.X.; Wang, M.; Yang, Y.; Zhang, Y. Comparative transcriptome analyses reveal conserved and distinct mechanisms of the SDHI fungicide benzovindiflupyr inhibiting Colletotrichum. Phytopathology 2022, 112, 1255–1263. [Google Scholar] [CrossRef] [PubMed]
- Xu, C.Y.; Liang, X.Y.; Hou, Y.P.; Zhou, M.G. Effects of the novel fungicide benzothiostrobin on Sclerotinia sclerotiorum in the laboratory and on Sclerotinia stem rot in rape fields. Plant Dis. 2015, 99, 969–975. [Google Scholar] [CrossRef] [PubMed]
- Erental, A.; Dickman, M.B.; Yarden, O. Sclerotial development in Sclerotinia sclerotiorum: Awakening molecular analysis of a “Dormant” structure. Fungal Biol. Rev. 2008, 22, 6–16. [Google Scholar] [CrossRef]
- Trippe, R.C., III; Pilon-Smits, E.A.H. Selenium transport and metabolism in plants: Phytoremediation and biofortification implications. J. Hazard. Mater. 2021, 404, 124178. [Google Scholar] [CrossRef] [PubMed]
- Sun, Y.; Wang, Y.; Xie, Z.Y.; Guo, E.H.; Han, L.R.; Zhang, X.; Feng, J.T. Activity and biochemical characteristics of plant extract cuminic acid against Sclerotinia sclerotiorum. Crop Prot. 2017, 101, 76–83. [Google Scholar] [CrossRef]
- Luo, J.J.; Li, Z.B.; Wang, J.J.; Weng, Q.F.; Chen, S.H.; Hu, M.Y. Antifungal activity of isoliquiritin and its inhibitory effect against Peronophythora litchi Chen through a membrane damage mechanism. Molecules 2016, 21, 237. [Google Scholar] [CrossRef] [PubMed]
- Wang, H.X.; Fu, L.; Li, C.L.; Zhang, X.L.; Narcisse, K.E.; Qi, H.S.; Han, C.Y.; Wang, X.Y.; Ma, H.B.; Zhu, C.Y.; et al. Tannic acid exerts antifungal activity in vitro and in vivo against Alternaria alternata causing postharvest rot on apple fruit. Physiol. Mol. Plant Pathol. 2023, 125, 102012. [Google Scholar] [CrossRef]
- Hohmann, S. An integrated view on a eukaryotic osmoregulation system. Curr. Genet. 2015, 61, 373–382. [Google Scholar] [CrossRef] [PubMed]
- Heller, A.; Witt-Geiges, T. Oxalic acid has an additional, detoxifying function in Sclerotinia sclerotiorum pathogenesis. PLoS ONE 2013, 8, e72292. [Google Scholar] [CrossRef] [PubMed]
- Nehela, Y.; Mazrou, Y.S.A.; ELGammal, N.A.; Atallah, O.; Abdelrhim, A.S.; Kumar, S.; Ahmed, T.; Ail, Q.; Makhlouf, A.H.; Hussain, W.A.M. Ornithine enhances common bean growth and defense against white mold disease via interfering with SsOAH and diminishing the biosynthesis of oxalic acid in Sclerotinia sclerotiorum. Front. Plant Sci. 2025, 16, 1483417. [Google Scholar] [CrossRef] [PubMed]
- Ding, L.N.; Li, T.; Guo, X.J.; Li, M.; Liu, X.Y.; Cao, J.; Tan, X.L. Sclerotinia stem rot resistance in rapeseed: Recent progress and future prospects. J. Agric. Food Chem. 2021, 69, 2965–2978. [Google Scholar] [CrossRef] [PubMed]
- Tóth, D.; Tengölics, R.; Aarabi, F.; Karlsson, A.; Vidal-Meireles, A.; Kovács, L.; Kuntam, S.; Körmöczi, T.; Fernie, A.R.; Hudson, E.P.; et al. Chloroplastic ascorbate modifies plant metabolism and may act as a metabolite signal regardless of oxidative stress. Plant Physiol. 2024, 196, 1691–1711. [Google Scholar] [CrossRef] [PubMed]
- Chu, C.C.; Han, C.Y.; Li, H. High-efficiency leucoplast transit peptides for manipulating plastid protein production. Nat. Plants 2025, 11, 1316–1324. [Google Scholar] [CrossRef] [PubMed]
- Awual, M.R.; Hasan, M.M.; Ihara, T.; Yaita, T. Mesoporous silica based novel conjugate adsorbent for efficient selenium (IV) detection and removal from water. Microporous Mesoporous Mater. 2014, 197, 331–338. [Google Scholar] [CrossRef]
- Vinceti, M.; Filippini, T.; Wise, L.A. Environmental selenium and human health: An update. Curr. Environ. Health Rep. 2018, 5, 464–485. [Google Scholar] [CrossRef] [PubMed]
- Dinh, Q.T.; Cui, Z.W.; Huang, J.; Tran, T.A.T.; Wang, D.; Yang, W.X.; Zhou, F.; Wang, M.K.; Yu, D.S.; Liang, D.L. Selenium distribution in the Chinese environment and its relationship with human health: A review. Environ. Int. 2018, 112, 294–309. [Google Scholar] [CrossRef] [PubMed]
- Natasha; Shahid, M.; Niazi, N.K.; Khalid, S.; Murtaza, B.; Bibi, I.; Rashid, M.I. A critical review of selenium biogeochemical behavior in soil-plant system with an inference to human health. Environ. Pollut. 2018, 234, 915–934. [Google Scholar] [CrossRef] [PubMed]

| Ratios of Sodium Selenite and Cuminic Acid | Virulence Equation | Correlation Coefficient | EC50(th) w (mg/L) | EC50(me) x (mg/L) | EC90(me) y (mg/L) | SR z |
|---|---|---|---|---|---|---|
| Sodium selenite | y = 3.1251x − 2.2107 | 0.9974 | - | 202.93 | 521.12 | - |
| Cuminic acid | y = 2.7659x + 0.3307 | 0.9953 | - | 48.77 | 141.56 | - |
| 1:1 | y = 4.7524x − 3.4345 | 0.9289 | 78.64 | 59.54 | 110.69 | 1.32 |
| 1:2 | y = 4.7942x − 2.7260 | 0.9172 | 65.31 | 40.88 | 75.60 | 1.60 |
| 1:3 | y = 4.5355x − 2.2095 | 0.9647 | 60.20 | 38.87 | 74.44 | 1.55 |
| 1:6 | y = 2.1448x + 1.6208 | 0.9505 | 54.71 | 37.63 | 148.70 | 1.45 |
| 1:10 | y = 2.3250x + 1.1969 | 0.9614 | 52.39 | 43.23 | 153.56 | 1.21 |
| Treatment | Detached Leaves of Rapeseed | Potted Plants of Rapeseed | ||
|---|---|---|---|---|
| Lesion Area (cm2) a | Control Efficacy (%) b | Lesion Area (cm2) | Control Efficacy (%) | |
| Selenium Mixture 800 mg/L | 1.49 ± 0.35 | 44.72 ± 3.12 | 1.71 ± 0.18 | 30.24 ± 3.48 |
| Water Control | 5.33 ± 1.08 | - | 3.78 ± 0.69 | - |
Disclaimer/Publisher’s Note: The statements, opinions and data contained in all publications are solely those of the individual author(s) and contributor(s) and not of MDPI and/or the editor(s). MDPI and/or the editor(s) disclaim responsibility for any injury to people or property resulting from any ideas, methods, instructions or products referred to in the content. |
© 2025 by the authors. Licensee MDPI, Basel, Switzerland. This article is an open access article distributed under the terms and conditions of the Creative Commons Attribution (CC BY) license (https://creativecommons.org/licenses/by/4.0/).
Share and Cite
Zhang, X.; Hou, Y.; Ma, X.; Sun, X.; Chen, Q.; Wu, L.; Zhang, C. Inhibitory Effects and Underlying Mechanisms of a Selenium Compound Agent Against the Pathogenic Fungus Sclerotinia sclerotiorum Causing Sclerotinia Stem Rot in Brassica napus. Agronomy 2025, 15, 1764. https://doi.org/10.3390/agronomy15081764
Zhang X, Hou Y, Ma X, Sun X, Chen Q, Wu L, Zhang C. Inhibitory Effects and Underlying Mechanisms of a Selenium Compound Agent Against the Pathogenic Fungus Sclerotinia sclerotiorum Causing Sclerotinia Stem Rot in Brassica napus. Agronomy. 2025; 15(8):1764. https://doi.org/10.3390/agronomy15081764
Chicago/Turabian StyleZhang, Xiaojuan, Yangzi Hou, Xiuqi Ma, Xiaomin Sun, Qiao Chen, Lele Wu, and Chenlu Zhang. 2025. "Inhibitory Effects and Underlying Mechanisms of a Selenium Compound Agent Against the Pathogenic Fungus Sclerotinia sclerotiorum Causing Sclerotinia Stem Rot in Brassica napus" Agronomy 15, no. 8: 1764. https://doi.org/10.3390/agronomy15081764
APA StyleZhang, X., Hou, Y., Ma, X., Sun, X., Chen, Q., Wu, L., & Zhang, C. (2025). Inhibitory Effects and Underlying Mechanisms of a Selenium Compound Agent Against the Pathogenic Fungus Sclerotinia sclerotiorum Causing Sclerotinia Stem Rot in Brassica napus. Agronomy, 15(8), 1764. https://doi.org/10.3390/agronomy15081764
